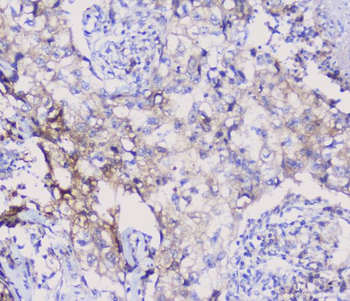
NSE/ENO2 Antibody
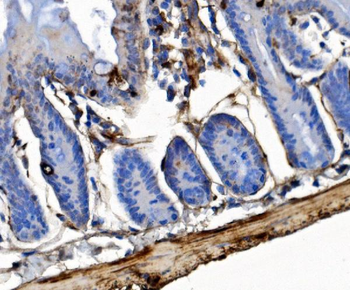
Integrin linked ILK Antibody

You have no items in your shopping cart.
- Featured

IF, IHC-Fr, IHC-P
Human, Mouse, Rat
Bovine, Canine, Equine, Porcine, Rabbit
Rabbit
Polyclonal
Unconjugated
50 μl, 100 μl, 200 μl - Featured

FC, IF, IHC-Fr, IHC-P
Human, Mouse, Rat
Bovine, Canine, Equine, Porcine, Rabbit
Rabbit
Polyclonal
Unconjugated
50 μl, 100 μl, 200 μl - Featured

IF, IHC-Fr, IHC-P, WB
Human, Mouse, Rat
Bovine, Canine, Equine, Gallus, Porcine, Rabbit
Rabbit
Polyclonal
Unconjugated
50 μl, 100 μl, 200 μl - Featured

FC, IF, IHC-Fr, IHC-P, WB
Human, Mouse, Rat
Bovine, Equine, Gallus, Porcine, Rabbit
Rabbit
Polyclonal
Unconjugated
100 μl, 50 μl, 200 μl - Featured

FC, ICC, IF, IHC-Fr, IHC-P, WB
Human, Mouse, Rat
Mouse, Rat
Rabbit
Polyclonal
Unconjugated
100 μl, 200 μl, 50 μl - Featured

FC, ICC, IF, IHC-Fr, IHC-P, WB
Human, Mouse, Rat
Bovine, Canine, Equine, Porcine
Rabbit
Polyclonal
Unconjugated
100 μl, 50 μl, 200 μl - Featured

IF, IHC-Fr, IHC-P, WB
Mouse
Human, Monkey, Rat
Rabbit
Polyclonal
Unconjugated
100 μl, 50 μl, 200 μl - ENO1 Antibody [orb688876]
ELISA, FC, IF, IP, WB
Human, Mouse, Rabbit, Rat
Mouse
Monoclonal
Unconjugated
50 μl, 100 μl - NSE/ENO2 Antibody [orb443177]Featured

FC, ICC, IF, IHC, WB
Human, Mouse, Rat
Rabbit
Polyclonal
Unconjugated
100 μg - Integrin linked ILK Antibody [orb763178]
ELISA, FC, ICC, IF, IHC, WB
Human, Mouse, Rat
Rabbit
Polyclonal
Unconjugated
100 μg